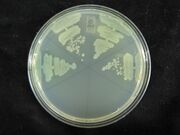

Uploads by Eric W Jones
From OpenWetWare
Jump to navigationJump to search
This special page shows all uploaded files.
| Date | Name | Thumbnail | Size | Description |
|---|---|---|---|---|
| 02:43, 4 October 2012 | 30 Ctr.JPG (file) | |
2.18 MB | |
| 19:47, 10 July 2012 | Cre PCR 7 10 2012.tif (file) |  |
2.35 MB | |
| 17:40, 5 July 2012 | 07052012CreTransformation.tif (file) |  |
2.35 MB | |
| 22:23, 2 July 2012 | 07July2012CreLowMelt.tif (file) |  |
2.35 MB | |
| 19:52, 28 June 2012 | 06282012LowMeltpIG12andAudrey.tif (file) |  |
2.35 MB | |
| 18:39, 28 June 2012 | CreAndJustin06282012.tif (file) |  |
2.35 MB | |
| 18:37, 28 June 2012 | CreAndJustin06232012.tif (file) |  |
2.35 MB | |
| 14:23, 7 May 2012 | RNA-2001-Flamm-254-65.pdf (file) | 314 KB | Design of multistable RNA molecules | |
| 16:54, 3 May 2012 | Thermoswitch.pdf (file) | 228 KB | Generation of synthetic RNA-based thermosensors Waldminghaus, Torsten; Kortmann, Jens; Gesing, Stefan; Narberhaus, Franz | |
| 16:48, 3 May 2012 | Listeriathermoswitch.pdf (file) | 469 KB | An RNA Thermosensor Controls Expression of Virulence Genes in Listeria monocytogenes Jörgen Johansson, Pierre Mandin, Adriana Renzoni, Claude Chiaruttini, Mathias Springer, Pascale Cossart In Listeria monocytogenes, virulence genes are maximally expresse | |
| 16:31, 3 May 2012 | 1-s2.0-S0006349511005145-main.pdf (file) | 977 KB | ||
| 16:24, 3 May 2012 | Gkr314.pdf (file) | 5.72 MB | Modulation of the stability of the Salmonella fourU-type RNA thermometer Jörg Rinnenthal, Birgit Klinkert, Franz Narberhaus, and Harald Schwalbe RNA thermometers are translational control elements that regulate the expression of bacterial heat shock and | |
| 21:08, 22 March 2012 | Igem cholera 03-22-12.tif (file) |  |
2.35 MB | Gel with Cre Lox on it. |
| 19:41, 20 March 2012 | First Gel Run Lox QBP 3-20-12.tif (file) |  |
2.35 MB | Lox colony PCR gel. Only colony 1 had the lox insert |
| 18:59, 13 March 2012 | Hill and Brian 007.JPG (file) |  |
1.99 MB |